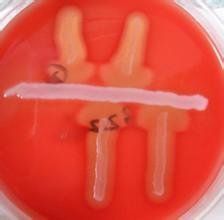
血漿凝固酶

簡介
血漿凝固酶血漿凝固酶:是多數致病菌株能產生凝固酶,能使含有肝素等抗凝劑的人或兔血漿發生凝固的酶類物質,致病株大多數能產生,是鑑別葡萄球菌有無致病性的重要指標.
金黃色葡萄球菌血漿凝固酶實驗
取肉湯培養物0.3mL同0.5mL凝固酶試驗兔血漿於8mm×100mm試管內充分混合,置 36±1℃培養,定時觀察是否有凝塊形成,至少觀察6 h,以內容物完全凝固,使試管倒置或 傾斜時不流動者為陽性。試驗中需同時做巳知 陽性和陰性對照。
血漿凝固酶是分子生物學上的專業術語,指的是能使含有肝素等抗凝劑的人或兔血漿發生凝固的酶類物質。血漿凝固酶:是多數致病菌株能產生凝固酶,能使含有肝素等抗凝劑的人或兔血漿發生凝固的酶類物質,致病株大多數能產生,是鑑別葡萄球菌有無致病性的重要指標.
血漿凝固酶血漿凝固酶:是多數致病菌株能產生凝固酶,能使含有肝素等抗凝劑的人或兔血漿發生凝固的酶類物質,致病株大多數能產生,是鑑別葡萄球菌有無致病性的重要指標.
取肉湯培養物0.3mL同0.5mL凝固酶試驗兔血漿於8mm×100mm試管內充分混合,置 36±1℃培養,定時觀察是否有凝塊形成,至少觀察6 h,以內容物完全凝固,使試管倒置或 傾斜時不流動者為陽性。試驗中需同時做巳知 陽性和陰性對照。
葡萄球菌是臨床較常見的感染菌,隨著大量頭孢菌素尤其是第三代頭孢菌素等高效廣譜抗菌藥物的廣泛使用,耐甲氧西林葡萄球菌(MRS)在全球範圍內不斷增加,耐甲氧...
簡介 性狀 致病性一種由葡萄球菌產生的酶。具有類似凝血酶原激酶的活性,能使經檸檬酸或草酸處理過的血漿凝固。
原理 方法 血漿凝固酶實驗已是必然需要。下面介紹實驗室常用的MRCNS的鑑定方法。 血漿凝固酶鑑定方法血漿凝固酶玻片法、試管法材料 菌株為實驗室保存菌株,新鮮未稀釋的兔...凝固酶。方法評價公認採用兔血漿較好,目前許多實驗室用病人血漿或血庫血漿來...
血液從流動的液體狀態變成不能流動的膠凍狀凝塊的過程即為血液凝固(blood coagulation)。這是由凝血因子參與的一系列蛋白質有限水解的過程。血...
凝血因子 發生機理 套用研究 所屬分類ELISA(酶聯免疫吸附試驗,酶聯免疫試劑盒) (以下簡稱ELISA(酶聯免疫吸附試驗,酶聯免疫試劑盒)) :是酶免疫測定技術中套用最廣的技術。其基本方...
種類 酶聯免疫試劑盒的使用 試劑盒血漿的主要作用是運載血細胞,運輸維持人體生命活動所需的物質和體內產生的廢物等。血漿相當於結締組織的細胞間質。血漿是血液的重要組成部分,呈淡黃色液體(因含...
主要成分 理化性質 區別 數據測算血液凝固分析儀是血栓與止血分析的專用儀器,可檢測多種血栓與止血指標,為出血和血栓性疾病診斷、溶栓與抗凝治療監測及療效觀察提供了有價值的指標,是目前血栓/...
基本介紹 血凝儀的基本原理 血栓與止血的檢測指標及可用的原理血漿蛋白是血漿中最主要的固體成分,含量為60~80g/L,血漿蛋白質種類繁多,功能各異。用不同的分離方法可將血漿蛋白質分為不同的種類。
概述 組成 分類 共同特徵 主要功能